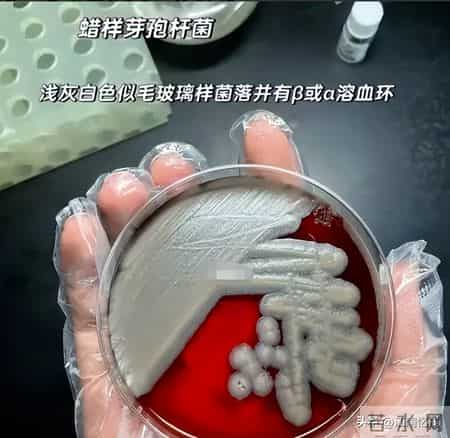
知名奶粉爆雷，含致病菌隐患威胁孩子健康，很多家庭仍在使用

有句话说得好:“祸从口出,病从口入”
尤其是对于新生宝宝而言,平日里所食用的奶粉质量至关重要。
然而,最近一则有关一知名奶粉含有病菌隐患的消息迅速在网上传开,这也使得不少宝妈宝爸们感到揪心,生怕自家宝宝也食用了这种奶粉而危害到宝宝的健康。

文|图图
看图文更过瘾! 关注我,精彩不断!下方留言区已开放,等你来畅所欲言!#关注有惊喜#头号创作者激励计划#
那么,到底是哪些奶粉使得这些宝妈宝爸们如此恐慌呢?

2026年1月5日,瑞士食品巨头雀巢公司发布声明,因供应商提供的原料存在“质量问题”,在德国、奥地利、丹麦、意大利、瑞典等多个欧洲国家预防性召回一批婴儿配方奶粉。
声明中,雀巢公司确认已对可能受影响的产品进行了花生四烯酸油脂及相关油脂混合物检测,并公布了召回产品的图片和批次编号。

这次召回在短短几天内迅速扩大范围。
最初在2025年12月10日,只有雀巢Nan Expertpro Sensilac 1被召回。但到2026年1月初,召回产品已扩大到八个品种。

一些家长们在手机上仔细核对着批次号,冷汗直冒。那些数字字母的组合,和自家奶粉罐底部的标识完全吻合。

问题根源是生产环境中检测到的蜡样芽孢杆菌。这种细菌产生的毒素cereulide,可能导致婴儿出现腹泻、呕吐等症状。

丹麦兽医和食品管理局发出警告,由于婴幼儿免疫系统尚未发育完全,对这种细菌感染特别脆弱。
沙特食品和药品管理局也迅速跟进,警告消费者不要食用雀巢生产的NAN、ALFAMINO、S6 GOLD和S6 ULTIMA等品牌的部分批次产品。
虽然雀巢公司表示“尚未确认任何与相关产品相关的疾病病例”,并称这是“预防性和自愿性召回”,但对于大多数家长来说,这无疑是一颗定时炸弹。

在中国,许多家庭偏好购买进口奶粉,认为其质量更有保障。
有不少家长以为花了高价就能买到安全。而现在,他们必须面对一个现实:即使是知名国际品牌,也可能存在安全隐患。

有不少家长立刻按照召回通知上的指示停止使用该产品,并联系了购买渠道。然而,由于是通过非正规代购购买,退货退款的过程异常复杂。
与此同时,欧洲的超市和药店已经开始下架相关产品。雀巢公司提供了消费者咨询电话,并承诺为受影响的产品提供退货及退款服务。

营养师于良指出,选择婴儿奶粉时,必须确保产品符合国家标准。
正规渠道进口的奶粉会经过严格检验,而“海淘奶粉未必能够符合我国的标准。
例如,在中国标准中,乳清蛋白和酪蛋白的比例要求为6:4,而一些西方国家的标准是5:5。

如果买到的是假冒伪劣的奶粉,会对孩子造成严重的危害。
近年来,奶粉安全事件时有发生,从2008年的三聚氰胺事件到2020年湖南郴州固体饮料冒充特医食品事件,每次都给无数家庭带来伤害。
专家指出,对于已经受到问题奶粉影响的孩子,应及时到医院进行营养筛查,根据专业医生的建议进行干预。

这次事件让无数家庭深刻认识到,婴幼儿食品安全无小事。即使是国际知名品牌,也可能因为供应链问题出现安全隐患。
雀巢公司在声明中表示:“我们理解父母们可能担心,我们非常重视消费者的所有反馈。” 同时,公司强调已停止使用特定供应商的原料。

食品安全专家指出,这次事件凸显了全球供应链管理的复杂性。一个供应商的问题可能影响到多个国家的产品,而快速透明的信息传递至关重要。

欧盟国家的食品安全监管机构已经加强了对婴儿配方奶粉的监控。
在中国,相关部门也应加强对进口奶粉的检验,特别是通过非正规渠道流入市场的产品。

家长们现在成为了一个更加警觉的消费者。他们会仔细检查每罐奶粉的批次号、生产日期和保质期,只从可靠渠道购买,并且定期关注食品安全预警信息。
对于宝宝来说,这段经历可能很快就会被遗忘。但对于他们的父母来说,这是一次深刻的教训:在孩子的食品安全问题上,永远不能掉以轻心。
本站是社保查询公益性网站链接,数据来自各地人力资源和社会保障局,具体内容以官网为准。
定期更新查询链接数据 苏ICP备17010502号-11